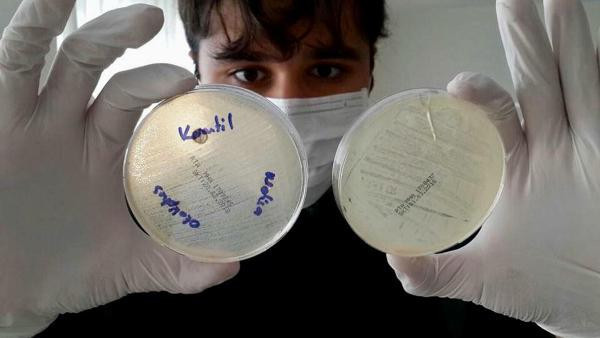
TÜBİTAK'ın kabul etmediği projeye Harvard talip oldu - Resim: 3

TÜBİTAK'ın kabul etmediği projeye Harvard talip oldu

MANİSA'da özel okul öğrencilerinin melisa, okaliptüs ve karanfil yağlarının havadaki bakterileri temizleme özelliğiyle ilgili araştırması, TÜBİTAK tarafından 'eksik belge' nedeniyle kabul edilmemesine rağmen ABD'deki Harvard Üniversitesi'nden davet aldı.

MANİSA'da özel okul öğrencilerinin TÜBİTAK tarafından 'eksik belge' nedeniyle kabul görmeyen 2 projesi, Harvard Üniversitesi'nin ilgisini çekti. Harvard'dan kimya ve biyoloji alanındaki çalışmalarıyla davet alan 4 öğrenci, büyük gurur yaşadı. Biyoloji öğretmeni Nuray Avcı eşliğinde 10'uncu sınıf öğrencisi Göktuğ Altıparmak ve 11'inci sınıf öğrencisi Seda Erol'un melisa, okaliptüs ve karanfil yağlarının havadaki bakteriler üzerindeki etkisi ve bu yağların bakterileri temizlemesine yönelik projesi, büyük ilgi gördü.

Harvard Üniversitesi'nden davet alan projeyi anlatan biyoloji öğretmeni Nuray Avcı, "Projemizi ağustos ayından bu yana hazırlıyoruz. İnsanların toplu olarak yaşadığı hastaneler, toplu taşıma araçları, okullar gibi alanlarda üst solunum yolu hastalıklarının çoğaldığını tespit ettik. Bununla ilgili olarak havalandırmaların rutin temizliğinin yapılması gerekiyor; ancak bu temizlikte kullanılan maddeler tamamen kimyasal olup, alerjiye neden olabiliyor. Biz yaptığımız çalışmada doğal ürünler olan aynı zamanda antiseptik özelliğini bildiğimiz melisa, okaliptus ve karanfil yağlarını kullandık. TÜBİTAK için başvurduğumuz bu proje için Harvard'dan davet aldık" dedi.
HAVADAKİ BAKTERİLERİN ÜREMESİ ENGELLENİYOR... 11'inci sınıf öğrencisi Seda Erol ise çok mutlu olduklarını belirterek, "Klima filtrelerinden örnekler aldık, bakterilerin kolonileşmesini gözlemledik. Ardından bitkisel yağların etkisini araştırdık ve melisa, okaliptus ve karanfil yağlarını bakterilerin üremesini önemli derecede sınırlandırdığını, hatta azalttığını gözlemledik. Yaptığımız proje sonunda Harvard'da bilimsel konferans sunumu için davet aldık. Çok heyecanlıyız ve çok mutluyuz" diye konuştu.

'CANLARI SAĞ OLSUN'... 10'uncu sınıf öğrencisi Göktuğ Altıparmak da ucuz maliyetli gaz antiseptik üretmeyi hedeflediklerini dile getirerek, "Normalde klima filtrelerimizi temizlemeyi amaçlamıştık ancak havadaki bakterileri ciddi miktarda azalttığımızı gözlemledik. Kanserli hastaların akciğerleri bakterilere karşı daha dirençsiz oluyor, bunlara da çok ciddi bir yarar sağlayabileceğini düşünüyorum. Projemiz TÜBİTAK'tan kabul göremedi; ama canları sağ olsun. Sonuçta ülkemiz için çalışıyoruz. Harvard'dan davet aldık, oraya gideceğiz" dedi.